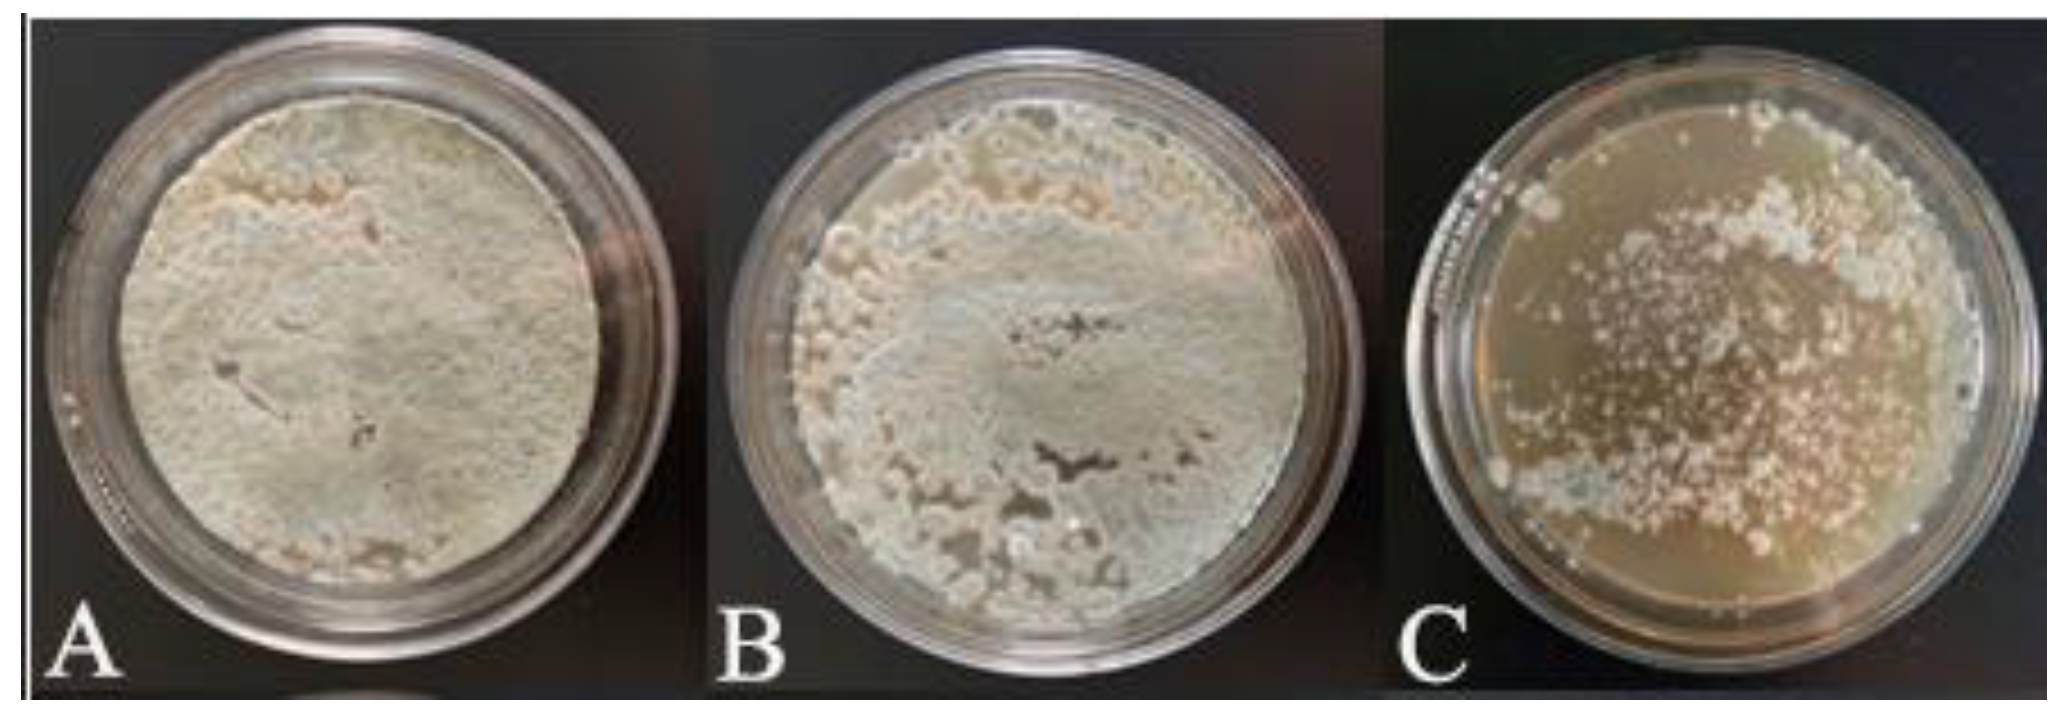
Horticulturae 08 01178 g002 Horticulturae 08 01178 g002

Effect of Leaf Extract from Lycium barbarum on Preservation of Cherry Tomato Fruit
Abstract
1. Introduction
2. Materials and Methods
2.1. Plant Material
2.2. Active Substance Contents
2.3. Determination of Freshness Indicators for Cherry Tomatoes
2.4. Antioxidant Activity Assay
2.5. Antifungal Capacity Assay
2.6. Statistical Analyses
3. Results
3.1. Contents of Active Substances in Lycium barbarum Leaf Extract
3.2. Antioxidant Capacity and Antifungal Activity of Lycium barbarum Leaf Extract
3.3. Effects of Different Lycium barbarum Leaf Extract Concentrations on Weight Loss by Cherry Tomatoes
3.4. Effects of Different Lycium barbarum Leaf Extract Concentrations on the Brightness (L) of Cherry Tomatoes
3.5. Effects of Different Lycium barbarum Leaf Extract Concentrations on the Firmness of Cherry Tomatoes
3.6. Effects of Different Lycium barbarum Leaf Extract Concentrations on the Chromaticity (a/b) of Cherry Tomatoes
3.7. Effects of Different Lycium barbarum Leaf Extract Concentrations on the Vitamin C Content of Cherry Tomato
3.8. Effect of Different Lycium barbarum Leaf Extract Concentrations on SOD Enzyme Activities of Cherry Tomato
3.9. Effects of Different Lycium barbarum Leaf Extract Concentrations on TSS Content of Cherry Tomatoes
3.10. Effects of Different Lycium barbarum Leaf Extract Concentrations on TA Content of Cherry Tomatoes
4. Discussion
5. Conclusions
Author Contributions
Funding
Acknowledgments
Conflicts of Interest
References
- Warnock, S.J. A Review of Taxonomy and Phylogeny of the Genus Lycopersicon. HortScience 1988, 23, 669–673. [Google Scholar] [CrossRef]
- Hou, Y.; Gao, J.; Gu, L.; Wang, S.; Zeng, R. Effects of Agaro-Oligosaccharide Treatment on Postharvest Quality of Cherry Tomatoes during Cold Storage. J. Food Process. Preserv. 2015, 39, 949–955. [Google Scholar] [CrossRef]
- Coyago-Cruz, E.; Corell, M.; Moriana, A.; Hernanz, D.; Stinco, C.M.; Melendez-Martinez, A.J. Effect of the fruit position on the cluster on fruit quality, carotenoids, phenolics and sugars in cherry tomatoes (Solanum lycopersicum L.). Food Res. Int. 2017, 100, 804–813. [Google Scholar] [CrossRef] [PubMed]
- Melendez-Martinez, A.J.; Mapelli-Brahm, P.; Benitez-Gonzalez, A.; Stinco, C.M. A comprehensive review on the colorless carotenoids phytoene and phytofluene. Arch. Biochem. Biophys. 2015, 572, 188–200. [Google Scholar] [CrossRef]
- Wabali, V.C.; Esiri, A.; Zitte, L. A sensory assessment of color and textural quality of refrigerated tomatoes preserved with different concentrations of potassium permanganate. Food Sci. Nutr. 2017, 5, 434–438. [Google Scholar] [CrossRef]
- Choi, D.S.; Park, S.H.; Choi, S.R.; Kim, J.S.; Chun, H.H. The combined effects of ultraviolet-C irradiation and modified atmosphere packaging for inactivating Salmonella enterica serovar Typhimurium and extending the shelf life of cherry tomatoes during cold storage. Food Packag. Shelf Life 2015, 3, 19–30. [Google Scholar] [CrossRef]
- Wang, Y.; Yu, T.; Xia, J.; Yu, D.; Wang, J.; Zheng, X. Biocontrol of postharvest gray mold of cherry tomatoes with the marine yeast Rhodosporidium paludigenum. Biol. Control 2010, 53, 178–182. [Google Scholar] [CrossRef]
- Zhu, Z.; Zhang, X. Effect of harpin on control of postharvest decay and resistant responses of tomato fruit. Postharvest Biol. Technol. 2016, 112, 241–246. [Google Scholar] [CrossRef]
- Ayala-Zavala, J.F.; Oms-Oliu, G.; Odriozola-Serrano, I.; González-Aguilar, G.A.; Álvarez-Parrilla, E.; Martín-Belloso, O. Bio-preservation of fresh-cut tomatoes using natural antimicrobials. Eur. Food Res. Technol. 2007, 226, 1047–1055. [Google Scholar] [CrossRef]
- Liu, H.; Meng, F.; Miao, H.; Chen, S.; Yin, T.; Hu, S.; Shao, Z.; Liu, Y.; Gao, L.; Zhu, C.; et al. Effects of postharvest methyl jasmonate treatment on main health-promoting components and volatile organic compounds in cherry tomato fruits. Food Chem. 2018, 263, 194–200. [Google Scholar] [CrossRef]
- Feng, L.; Zhang, M.; Adhikari, B.; Guo, Z. Application of high-pressure argon for improving postharvest quality of cherry tomato. J. Food Process Eng. 2018, 41, e12882. [Google Scholar] [CrossRef]
- Zeng, C.; Tan, P.; Liu, Z. Effect of exogenous ARA treatment for improving postharvest quality in cherry tomato (Solanum lycopersicum L.) fruits. Sci. Hortic. 2020, 261, 108959. [Google Scholar] [CrossRef]
- Paulsen, E.; Barrios, S.; Lema, P. Ready-to-eat cherry tomatoes: Passive modified atmosphere packaging conditions for shelf life extension. Food Packag. Shelf Life 2019, 22, 100407. [Google Scholar] [CrossRef]
- Rao, M.R.K.; Lakshmanan, V. Study of bio-preservative potential of turmeric on tomato. Indo Am. J. Pharm. Sci. 2018, 5, 3818–3829. [Google Scholar]
- Bastante, C.C.; Cardoso, L.C.; Fernández-Ponce, M.; Serrano, C.M.; de la Ossa, E.M. Supercritical impregnation of olive leaf extract to obtain bioactive films effective in cherry tomato preservation. Food Packag. Shelf Life 2019, 21, 100338. [Google Scholar] [CrossRef]
- Liu, X.; Zhang, X.; Zhang, X.; Li, F.; Tian, Y.; Du, M.; Zhao, H.; Shao, L. Antibacterial activity of Osmunda japonica (Thunb) polysaccharides and its effect on tomato quality maintenance during storage. Int. J. Food Sci. Technol. 2020, 55, 2851–2862. [Google Scholar] [CrossRef]
- Lei, Z.; Chen, X.; Cao, F.; Guo, Q.; Wang, J. Phytochemicals and bioactivities of Goji (Lycium barbarum L. and Lycium chinense Mill.) leaves and their potential applications in the food industry: A review. Int. J. Food Sci. Technol. 2021, 57, 1451–1461. [Google Scholar] [CrossRef]
- Rjeibi, I.; Feriani, A.; Saad, A.B.; Ncib, S.; Sdayria, J.; Hfaiedh, N.; Allagui, M.S. Lycium europaeum Linn as a source of polysaccharide with in vitro antioxidant activities and in vivo anti-inflammatory and hepato-nephroprotective potentials. J. Ethnopharmacol. 2018, 225, 116–127. [Google Scholar] [CrossRef] [PubMed]
- Yao, R.; Heinrich, M.; Weckerle, C.S. The genus Lycium as food and medicine: A botanical, ethnobotanical and historical review. J. Ethnopharmacol. 2018, 212, 50–66. [Google Scholar] [CrossRef] [PubMed]
- Chen, P.Y.; Shih, T.H.; Chang, K.C.; Wang, J.S.; Yang, C.M.; Chang, Y.S. Potential of galled leaves of Goji (Lycium chinense) as functional food. BMC Nutr. 2020, 6, 26. [Google Scholar] [CrossRef]
- Dong, J.Z.; Gao, W.S.; Lu, D.Y.; Wang, Y. Simultaneous Extraction and Analysis of Four Polyphenols from Leaves of Lycium barbarum L. J. Food Biochem. 2011, 35, 914–931. [Google Scholar] [CrossRef]
- Spano, M.; Maccelli, A.; Di Matteo, G.; Ingallina, C.; Biava, M.; Crestoni, M.E.; Bardaud, J.-X.; Giusti, A.M.; Mariano, A.; Scotto D’Abusco, A. Metabolomic Profiling of Fresh Goji (Lycium barbarum L.) Berries from Two Cultivars Grown in Central Italy: A Multi-Methodological Approach. Molecules 2021, 26, 5412. [Google Scholar] [CrossRef] [PubMed]
- Mocan, A.; Vlase, L.; Vodnar, D.C.; Bischin, C.; Hanganu, D.; Gheldiu, A.M.; Oprean, R.; Silaghi-Dumitrescu, R.; Crisan, G. Polyphenolic content, antioxidant and antimicrobial activities of Lycium barbarum L. and Lycium chinense Mill. leaves. Molecules 2014, 19, 10056–10073. [Google Scholar] [CrossRef] [PubMed]
- Conidi, C.; Drioli, E.; Cassano, A. Biologically Active Compounds from Goji (Lycium barbarum L.) Leaves Aqueous Extracts: Purification and Concentration by Membrane Processes. Biomolecules 2020, 10, 935. [Google Scholar] [CrossRef] [PubMed]
- Xu, Y.; Fan, M.; Ran, J.; Zhang, T.; Sun, H.; Dong, M.; Zhang, Z.; Zheng, H. Variation in phenolic compounds and antioxidant activity in apple seeds of seven cultivars. Saudi. J. Biol. Sci. 2016, 23, 379–388. [Google Scholar] [CrossRef] [PubMed]
- Parvaneh, T.; Abedi, B.; Davarynejad, G.H.; Moghadam, E.G. Enzyme activity, phenolic and flavonoid compounds in leaves of Iranian red flesh apple cultivars grown on different rootstocks. Sci. Hortic. 2019, 246, 862–870. [Google Scholar] [CrossRef]
- Zhang, X.X.; Shi, Q.Q.; Ji, D.; Niu, L.X.; Zhang, Y.L. Determination of the phenolic content, profile, and antioxidant activity of seeds from nine tree peony (Paeonia section Moutan DC.) species native to China. Food Res. Int. 2017, 97, 141–148. [Google Scholar] [CrossRef]
- Wan, Z.; Zhu, J.; Tian, R.; Yang, W.; Chen, Z.; Hu, Q.; Zeng, Z. Quality evaluation for Dipacus asperoides from Enshi areas and optimization extraction of saponins and organic acids and its application. Arab. J. Chem. 2021, 14, 103107. [Google Scholar] [CrossRef]
- Yuan, J.; Yan, X.; Chen, X.; Jiang, X.; Ye, K.; Xiong, Q.; Kong, J.; Huang, Y.; Jiang, C.; Xu, T. A mild and efficient extraction method for polysaccharides from Sinonovacula constricta and study of their structural characteristic and antioxidant activities. Int. J. Biol. Macromol. 2020, 143, 913–921. [Google Scholar] [CrossRef]
- Hadizadeh, M.; Ofoghi, H.; Kianirad, M.; Amidi, Z. Elicitation of pharmaceutical alkaloids biosynthesis by salicylic acid in marine microalgae Arthrospira platensis. Algal Res. 2019, 42, 101597. [Google Scholar] [CrossRef]
- Mendy, T.; Misran, A.; Mahmud, T.; Ismail, S. Application of Aloe vera coating delays ripening and extend the shelf life of papaya fruit. Sci. Hortic. 2019, 246, 769–776. [Google Scholar] [CrossRef]
- Buendía, L.; Soto, S.; Ros, M.; Antolinos, V.; Navarro, L.; Sánchez, M.J.; Martínez, G.B.; López, A. Innovative cardboard active packaging with a coating including encapsulated essential oils to extend cherry tomato shelf life. LWT 2019, 116, 108584. [Google Scholar]
- Zhang, X.; Zhang, X.; Liu, X.; Du, M.; Tian, Y. Effect of polysaccharide derived from Osmunda japonica Thunb-incorporated carboxymethyl cellulose coatings on preservation of tomatoes. J. Food Process. Preserv. 2019, 43, e14239. [Google Scholar] [CrossRef]
- Pobiega, K.; Przybył, J.L.; Żubernik, J.; Gniewosz, M. Prolonging the shelf life of cherry tomatoes by pullulan coating with ethanol extract of propolis during refrigerated storage. Food Bioprocess Technol. 2020, 13, 1447–1461. [Google Scholar] [CrossRef]
- Siqueira, J.D.; de Pellegrin, S.F.; Dos Santos, S.S.; Iglesias, B.A.; Piquini, P.C.; Arantes, L.P.; Soares, F.A.; Chaves, O.A.; Neves, A.; Back, D.F. SOD activity of new copper II complexes with ligands derived from pyridoxal and toxicity in Caenorhabditis elegans. J. Inorg. Biochem. 2020, 204, 110950. [Google Scholar] [CrossRef] [PubMed]
- Taiwo, B.R.; Kehinde, T.A. Antioxidant Properties, Sensory Evaluation and Mineral Content of Cardaba Banana and Plantain Flours. Open Agric. 2019, 4, 52–64. [Google Scholar] [CrossRef]
- Kondakci, E.; Ozyurek, M.; Guclu, K.; Apak, R. Novel pro-oxidant activity assay for polyphenols, vitamins C and E using a modified CUPRAC method. Talanta 2013, 115, 583–589. [Google Scholar] [CrossRef]
- Garcia, M.V.; Garcia-Cela, E.; Magan, N.; Copetti, M.V.; Medina, A. Comparative Growth Inhibition of Bread Spoilage Fungi by Different Preservative Concentrations Using a Rapid Turbidimetric Assay System. Front. Microbiol. 2021, 12, 678406. [Google Scholar] [CrossRef]
- Medina, A.; Lambert, R.J.; Magan, N. Rapid throughput analysis of filamentous fungal growth using turbidimetric measurements with the Bioscreen C: A tool for screening antifungal compounds. Fungal Biol. 2012, 116, 161–169. [Google Scholar] [CrossRef]
- Kadioğlu Yaman, B.; Şen, O.; Salman, A.; Sipahi, H.; Kúsz, N.; Hohmann, J.; Kirmizimekbez, H. Anti-inflammatory effects of Lycium barbarum leaf extracts in lipopolysaccharide-induced RAW 264.7 macrophage cells and isolation of secondary metabolites. J. Res. Pharm. 2019, 23, 750–758. [Google Scholar] [CrossRef]
- Dong, J.Z.; Lu, D.Y.; Wang, Y. Analysis of flavonoids from leaves of cultivated Lycium barbarum L. Plant Foods Hum. Nutr. 2009, 64, 199–204. [Google Scholar] [CrossRef] [PubMed]
- Pollini, L.; Rocchi, R.; Cossignani, L.; Manes, J.; Compagnone, D.; Blasi, F. Phenol Profiling and Nutraceutical Potential of Lycium spp. Leaf Extracts Obtained with Ultrasound and Microwave Assisted Techniques. Antioxidants 2019, 8, 260. [Google Scholar] [CrossRef] [PubMed]
- Wang, Y.; Zhao, B.; Ma, H.-R.; Aisa, H.A. Two new sesquiterpenoid glycosides from the leaves of Lycium barbarum. J. Asian Nat. Prod. Res. 2016, 18, 871–877. [Google Scholar] [CrossRef] [PubMed]
- Liu, S.-C.; Lin, J.-T.; Hu, C.-C.; Shen, B.-Y.; Chen, T.-Y.; Chang, Y.-L.; Shih, C.-H.; Yang, D.-J. Phenolic compositions and antioxidant attributes of leaves and stems from three inbred varieties of Lycium chinense Miller harvested at various times. Food Chem. 2017, 215, 284–291. [Google Scholar] [CrossRef] [PubMed]
- Sogvar, O.B.; Saba, M.K.; Emamifar, A. Aloe vera and ascorbic acid coatings maintain postharvest quality and reduce microbial load of strawberry fruit. Postharvest Biol. Technol. 2016, 114, 29–35. [Google Scholar] [CrossRef]
- Benhabiles, M.; Tazdait, D.; Abdi, N.; Lounici, H.; Drouiche, N.; Goosen, M.; Mameri, N. Assessment of coating tomato fruit with shrimp shell chitosan and N, O-carboxymethyl chitosan on postharvest preservation. J. Food Meas. Charact. 2013, 7, 66–74. [Google Scholar] [CrossRef]
- Park, M.-H.; Sangwanangkul, P.; Baek, D.-R. Changes in carotenoid and chlorophyll content of black tomatoes (Lycopersicone sculentum L.) during storage at various temperatures. Saudi J. Biol. Sci. 2018, 25, 57–65. [Google Scholar] [CrossRef]
- Islam, T.; Afrin, N.; Parvin, S.; Dana, N.; Rahman, K.; Zzaman, W.; Islam, M. The impact of chitosan and guava leaf extract as preservative to extend the shelf-life of fruits. Int. Food Res. J. 2018, 25, 2056–2062. [Google Scholar]
- Pinheiro, J.; Alegria, C.; Abreu, M.; Sol, M.; Gonçalves, E.M.; Silva, C.L. Postharvest Quality of Refrigerated Tomato Fruit (S olanum lycopersicum, cv. Z inac) at Two Maturity Stages Following Heat Treatment. J. Food Process. Preserv. 2015, 39, 697–709. [Google Scholar] [CrossRef]
- Wu, H.; Xue, N.; Hou, C.-l.; Feng, J.-t.; Zhang, X. Microcapsule preparation of allyl isothiocyanate and its application on mature green tomato preservation. Food Chem. 2015, 175, 344–349. [Google Scholar] [CrossRef]
- Yun, X.; Qi, X.; Zhang, Y.; Song, S.; Dong, T. Application of SiOx-coated poly (ε-caprolactone) film for preservation of cherry tomato. Polym. Polym. Compos. 2019, 28, 309–319. [Google Scholar] [CrossRef]
- Álvarez, A.; Manjarres, J.J.; Ramírez, C.; Bolívar, G. Use of an exopolysaccharide-based edible coating and lactic acid bacteria with antifungal activity to preserve the postharvest quality of cherry tomato. LWT 2021, 151, 112225. [Google Scholar] [CrossRef]
- Won, J.S.; Lee, S.J.; Park, H.H.; Song, K.B.; Min, S.C. Edible coating using a chitosan-based colloid incorporating grapefruit seed extract for cherry tomato safety and preservation. J. Food Sci. 2018, 83, 138–146. [Google Scholar] [CrossRef] [PubMed]
- Corpas, F.J.; Fernandez-Ocana, A.; Carreras, A.; Valderrama, R.; Luque, F.; Esteban, F.J.; Rodriguez-Serrano, M.; Chaki, M.; Pedrajas, J.R.; Sandalio, L.M.; et al. The expression of different superoxide dismutase forms is cell-type dependent in olive (Olea europaea L.) leaves. Plant Cell Physiol. 2006, 47, 984–994. [Google Scholar] [CrossRef] [PubMed]
- Razali, Z.; Somasundram, C.; Nurulain, S.Z.; Kunasekaran, W.; Alias, M.R. Postharvest Quality of Cherry Tomatoes Coated with Mucilage from Dragon Fruit and Irradiated with UV-C. Polymers 2021, 13, 2919. [Google Scholar] [CrossRef] [PubMed]
- Chun, O.K.; Kim, D.O.; Smith, N.; Schroeder, D.; Han, J.T.; Lee, C.Y. Daily consumption of phenolics and total antioxidant capacity from fruit and vegetables in the American diet. J. Sci. Food Agric. 2005, 85, 1715–1724. [Google Scholar] [CrossRef]
- Arima, H.; Ashida, H.; Danno, G.I. Rutin-enhanced Antibacterial Activities of Flavonoids against Bacillus cereus and Salmonella enteritidis. Biosci. Biotechnol. Biochem. 2002, 66, 1009–1014. [Google Scholar] [CrossRef]
- Lou, Z.; Wang, H.; Zhu, S.; Ma, C.; Wang, Z. Antibacterial Activity and Mechanism of Action of Chlorogenic Acid. J. Food Sci. 2011, 76, M398–M403. [Google Scholar] [CrossRef]
- Giuliano, G.; Bartley, G.E.; Scolnik, P.A. Regulation of carotenoid biosynthesis during tomato development. Plant Cell 1993, 5, 379–389. [Google Scholar]
- Helyes, L.D.J.P.Z.; Dimény, J.; Pék, Z.; Lugasi, A. Effect of maturity stage on content, color and quality of tomato (Lycopersicon lycopersicum (L.) Karsten) fruit. Int. J. Hortic. Sci. 2006, 12, 41–44. [Google Scholar] [CrossRef]

| Culture Solution | Absorption Value, OD600 |
|---|---|
| Penicillium | 0.90 ± 0.02 a |
| Penicillium + distilled water | 0.84 ± 0.01 b |
| Penicillium + Lycium barbarum leaf extract | 0.48 ± 0.01 c |
| Days | Treated with Distilled Water | No Treatment | Treated with 0.4 g/L Extract Solution |
|---|---|---|---|
| 0 | ![]() | ![]() | ![]() |
| 3 | ![]() | ![]() | ![]() |
| 6 | ![]() | ![]() | ![]() |
| 9 | ![]() | ![]() | ![]() |
| 12 | ![]() | ![]() | ![]() |
| 15 | ![]() | ![]() | ![]() |
| 18 | ![]() | ![]() | ![]() |
| 21 | ![]() | ![]() | ![]() |
| Days | Treated with Distilled Water | No Treatment | Treated with 1.0 g/L Extract Solution |
|---|---|---|---|
| 0 | ![]() | ![]() | ![]() |
| 7 | ![]() | ![]() | ![]() |
| 14 | ![]() | ![]() | ![]() |
| 21 | ![]() | ![]() | ![]() |
| 28 | ![]() | ![]() | ![]() |
| 35 | ![]() | ![]() | ![]() |
Publisher’s Note: MDPI stays neutral with regard to jurisdictional claims in published maps and institutional affiliations. |
© 2022 by the authors. Licensee MDPI, Basel, Switzerland. This article is an open access article distributed under the terms and conditions of the Creative Commons Attribution (CC BY) license (https://creativecommons.org/licenses/by/4.0/).
Share and Cite
Bu, H.; Ma, Y.; Ge, B.; Sha, X.; Ma, Y.; Zhang, P.; Jin, L. Effect of Leaf Extract from Lycium barbarum on Preservation of Cherry Tomato Fruit. Horticulturae 2022, 8, 1178. https://doi.org/10.3390/horticulturae8121178
Bu H, Ma Y, Ge B, Sha X, Ma Y, Zhang P, Jin L. Effect of Leaf Extract from Lycium barbarum on Preservation of Cherry Tomato Fruit. Horticulturae. 2022; 8(12):1178. https://doi.org/10.3390/horticulturae8121178
Chicago/Turabian StyleBu, Hubai, Yujia Ma, Beilei Ge, Xiaorong Sha, Ying Ma, Ping Zhang, and Lei Jin. 2022. "Effect of Leaf Extract from Lycium barbarum on Preservation of Cherry Tomato Fruit" Horticulturae 8, no. 12: 1178. https://doi.org/10.3390/horticulturae8121178
APA StyleBu, H., Ma, Y., Ge, B., Sha, X., Ma, Y., Zhang, P., & Jin, L. (2022). Effect of Leaf Extract from Lycium barbarum on Preservation of Cherry Tomato Fruit. Horticulturae, 8(12), 1178. https://doi.org/10.3390/horticulturae8121178











































